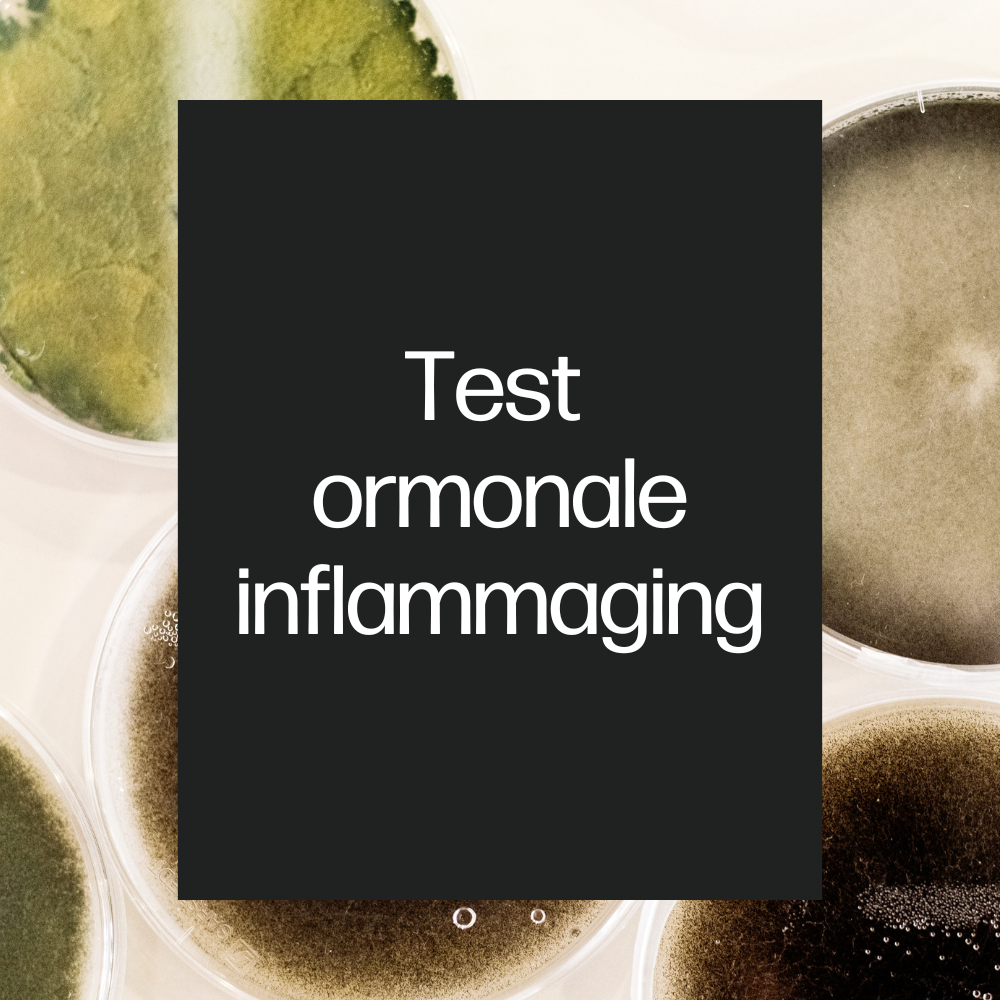

GS LOFT
Test Ormonale Inflammaging
Prezzo di listino
€310,00 EUR
Prezzo di listino
Prezzo di vendita
€310,00 EUR
Prezzo unitario
per
Imposte incluse.
Impossibile caricare la disponibilità di ritiro
Eseguito sempre tramite un campione di saliva, il test dello stress ossidativo analizza i radicali liberi e la potenza della propria barriera antiossidante. Il test permette di monitorare lo stress ossidativo, tra le principali cause dell’invecchiamento cellulare e degli effetti degenerativi, e comprendere il livello di inflammaging (infiammazione cronica di basso grado) per ridurre i livelli di stanchezza e di stress.